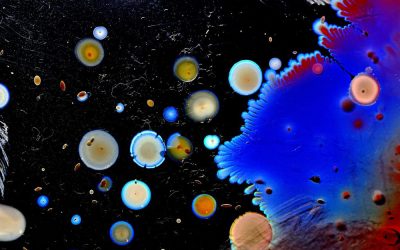
Just Rub Some Dirt on It

Blog
A Space Where Art & Science Meet
Just Rub Some Dirt on It
The recent release of a report titled, Vital Signs: Containment of Novel Multidrug-Resistant Organisms and Resistance Mechanisms from the CDC on drug-resistant organisms illustrates the pressing need for new antibiotics. “The emergence and spread of antibiotic...
read moreThe Sky is Falling!
If you are a follower of this blog you may now be wondering, what the heck is going on over there at DecoScience? They seem all little doom and gloom. We are only writing about what is current in the world of science, education, and/or art and a lot of crazy things...
read moreOn the Brink of Extinction?
This week saw the death of one of the last of his kind. Sudan, the male northern white rhino, was euthanized at the Ole Pejeeta Conservancy in Laikipia, Kenya after having a recurring infection in his leg. He was 45 years old. This leaves only 2 of his species left...
read moreAdventures in Antarctica
When picking a topic to write about on this blog, I often turn the internet for ideas that speak to me and to see what others are discussing. Recently there have been a couple of stories circulating on the internet about a land of almost mythical proportions way, way...
read moreStep Right Up and Meet the Amazing Talking Plants!
A walking, sentient plant has been the inspiration for writers since the early-mid 20th century including the Ents in J.R.R. Tolkien’s The Lord of the Rings, the Triffids in John Wyndham’s Day of the Triffids, and Audrey II from Little Shop of Horrors. Folklore and...
read moreA Quick Look at Bad Science and How to Spot It
Last week I wrote about conspiracy theories and the crazy stuff that people believe (link) but this week I am following that up with a guide to trying to figure out if a source is reliable. As I have stated before, the internet is a wondrous and horrible thing all at...
read morePeople Believe in the Strangest Things, But Why?
I am sure this too is a manipulation of the masses by shady forces of the lizard elite with their alien technology and HAARP mind control…All hail our squirrel and crow overlords! Oops, I let my alliances slip, again. A conspiracy theory is an explanation of an event...
read moreLet Me Introduce You to F.D.C. Willard, Physicist…Sort of
As a break from the usual blog about science, I would like to write a short biography about a physics researcher by the name of F.D.C. Willard. Full name: Felis domesticus Chester Willard. Wait, what? I knew cats were smart but who knew that one had authored a paper...
read moreWhat is This Madness of Which You Speak?
Let’s talk about physics! Wait, bear with me. Don’t roll your eyes at me; I promise you this will be interesting and if you are good, there may be bacon. A BBC Two video has recently been making the rounds again on social media and it is possibly one of the more...
read more